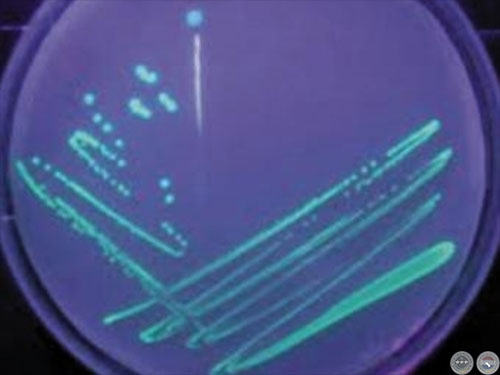

AZOSPIRILLUM BRASILIENSE PSEUDOMONAS FLUORESCENS
COMBINACIÓN EFECTIVA DE INOCULANTES PARA GRAMÍNEAS
Bioquímica LESLIE DUARTE
Introducción. Las bacterias promotoras de crecimiento vegetal (PGPRs) pueden afectar el crecimiento de las plantas de forma directa o indirecta. Una de las PGPR más estudiadas pertenece al género Azospirillum que son bacterias gram-negativas que se encuentran en el suelo, son aerobias o microaerófilas capaces de producir fitohormonas y de fijar nitrógeno del aire sin asociarse simbióticamente a las plantas.

El contenido de fósforo, nitrógeno, potasio y diversos micronutrientes son mayores en las plantas inoculadas con Azospirillum que en las no inoculadas, esto es gracias a todos los mecanismos por los cuales actúa esta bacteria en la promoción del crecimiento vegetal.
La mayor exploración radical permite acceder a sitios del suelo enriquecidos con nutrientes poco móviles como el fósforo. La Pseudomonas fluorescens es un bacilo gram-negativo, aeróbico, saprófito con pigmento fluorescente y tiene la capacidad de exudar ciertos ácidos orgánicos que promueven incrementos en las concentraciones de fósforo en las inmediaciones de las raíces.
AZOSPIRILLUM BRASILIENSE
La bacteria coloniza específicamente los lugares de emergencia de las raíces laterales y en las zonas de los pelos radicales, tanto de la raíz primaria como de las secundarias.

Colonización de las raíces.
Mecanismos principales por los cuales actúan
1. Producción de fitohormonas. Como el ácido 3-indolacético (AIA), que es sintetizado por la bacteria y liberado como producto de su metabolismo, el cual regula la división celular y la formación de raíces. En el laboratorio puede evidenciarse la producción de (AIA) por medio de una reacción colorimétrica según se observa en la Figura 1.
2. Fijación de nitrógeno atmosférico. Asimismo, la bacteria presenta la característica de fijación de nitrógeno, proporcionándole a la planta el elemento combinado para su incorporación. A nivel in vitro se evidencia en medios específicos semisólidos NFb con la formación de película, como puede apreciarse en la Figura 2.
PSEUDOMONAS FLUORESCENS
Esta bacteria tiene una alta capacidad de solubilización de fósforo y la realizan por dos vías principalmente.
1. Producción de ácidos orgánicos. Actúan sobre el pH del suelo favoreciendo la solubilización del fósforo inorgánico y liberando el fosfato a la solución del suelo.
2. A través de las fosfatasas. Actúan sobre las uniones ésteres liberando los grupos fosfatos de la materia orgánica a la solución del suelo.

También pueden producir:
Sustancias antagónicas y sideróforos.
Poseen actividad PGPR en las plantas.
VENTAJAS DE LOS INOCULANTES A BASE DE AZOSPIRILLUM PSEUDOMONAS
1. Mayor desarrollo radical inducido por la inoculación conduce a una mayor absorción de agua y nutrientes del suelo que se refleja en el mayor crecimiento del tallo y follaje.

2. Efectos positivos sobre el rendimiento en el 60-70% de los experimentos y que la inoculación permite disminuir las dosis de fertilizantes (NPK) en un 30-45% sin afectar significativamente los rendimiento.
3. No dañan el medio ambiente ni el suelo ya que son productos amigables con la naturaleza, además una vez utilizados estos productos las bacterias quedan colonizando el suelo, entonces para una próxima siembra producen un efecto sinérgico natural que se evidencia en los rendimientos.
4. Hasta 174% superior en la materia verde de un cultivo inoculado a los 75 días de siembra.

Conclusión. Se pueden observar las ventajas que presenta la utilización de inoculantes a base de Azospirillum brasiliense Pseudomonas fluorescens en las gramíneas, pudo evidenciarse científicamente a nivel laboratorio los mecanismos por los cuales actúan tanto en la producción de fitohormonas, fijación de nitrógeno, así como también la solubilización del fósforo para que sean asimilables, los que actúan simultáneamente mejorando la germinación, aumento del desarrollo radicular, mejorando el crecimiento vegetativo, calidad de los granos lo que finalmente desemboca en un mejor rendimiento y calidad. Además de resaltar que son productos que no dañan el medio ambiente ni el suelo.
Fuente en Internet:
ACTUALIDAD DEL CAMPO AGROPECUARIO
Tte. Vera 2856 e/ Cnel. Cabrera y Dr. Caballero
Telefax: (59521) 612 404 / 660 984
Asunción - Paraguay
E-mail: info@campoagropecuario.com.py